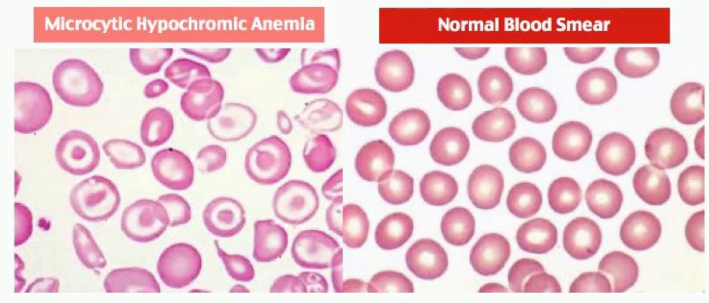

철결핍성 빈혈(IDA)은 소아에서 가장 흔한 빈혈의 원인입니다.
진단은 RBC index와 Lab 패널,
치료는 oral iron 중심으로 접근하며,
연령별 철분 권장량과 철분 반응의 시점을 알면 치료 경과를 정확히 해석할 수 있습니다.

IDA의 진단은 피검사를 통해서 이루어집니다.
빈혈의 정도가 심한 경우,
RBC index 소견으로 추정하고, 검사를 통해서 확진할수 있습니다.
IDA 철겹핍성 빈혈은
Microcytic, hypochromic anemia 소견을 보이기에,
MCV↓, MCH↓등의 수치가 변화가 보이므로, 이를 통해서 의심합니다.
빈혈이 심하지 않는 경우에는
철패널 검사라고 불리는 혈청내의 철분에 대한 검사가 필요합니다.
철겹핍시 피검사 소견은,
Ferritin ↓ (< 10~12 ng/mL) → 초기 민감 지표
Serum iron ↓ (< 60 μg/dL)
Transferrin saturation ↓ (< 10~16%)
TIBC (총철결합능력) ↑ (> 350~500 μg/dL)
FEP ↑ (헴 합성 장애 시 보조 지표)
이러한 소견을 보입니다.
말초 혈액도말에서는
→ 작고 창백한 RBC 확인되는데,
이를 microcytic hypochromic RBC 라고합니다.
위와같이 단일 검사만으로는 진단이 어렵고
위 지표들을 조합해서 종합적으로 판단하게됩니다.
치료는 철의 보충으로, 철 보충은 경구제로시행하게되며, 정맥제는 필요 없습니다.
1차 치료제는 Oral iron (경구 철분)으로
정맥제는 일반적으로 필요 없습니다.

제형은 Ferrous salt(2가) 를 사용하게되고,
이는 Ferric(3가) 대비 흡수율이 3배 이상입니다.
복용 시기는 흡수율을위해 공복 복용을 권장하지만, 위장 장애가 있을 수 있습니다.
철 복용의 흔한 부작용은 복통, 오심, 구토, 변비 입니다.
권장 용량은 (Elemental iron 기준)
연령/상태에 따라 다른데,
성인 IDA 치료는 60mg × 3회/day (최대 180~300mg/day)
소아 IDA 치료는 6mg/kg/day (최대 200mg/day 초과 X)
이정도입니다.

예방을 위해서는,
정상 만삭아는 34개월부터 12mg/kg/day
미숙아에서의 예방적인 목적은 2개월부터 1~4mg/kg/day
7~10세 아동은 10mg/day
11세 이상은 18mg/day
임신부는 6~7mg/day
이정도의 용량의 철분이 필요합니다.
IDA 빈혈에서 철분 치료에 따른 반응은 수치적으로는 즉각으로 나타나나 정상화되기까지는 꽤오랜 시간이 필요합니다.
12~24시간이후 세포 내 iron enzyme 회복이 시작되며,
36~48시간이후 골수 반응 개시로 RBC 생성이 시작되고,
3일 (72시간)이후 망상적혈구(reticulocyte) 증가가 시작되고
5~7일 후 망상적혈구가 최대치가됩니다.
3~4주일째에 Hb 상승이 뚜렷하며,
1~3개월째에 저장된 철 회복이 이루어집니다. (Ferritin ↑)
소아의 경우 Hb 수치의 정상화 후에도 2~3개월 추가 복용이 필요하며
성인은 6~12개월 유지하여 저장 철까지 회복시켜야 재발을 방지할수 있습니다

지금까지..
철결핍성 빈혈 iron deficiency anemia : 진단 지표와 철분 치료 용량 피검사 입니다.
'소아 혈액질환' 카테고리의 다른 글
| 유전구형적혈구증 Hereditary Spherocytosis (HS) 치료 – 비정절제술 수혈, 엽산 보충, 철분보충 (2) | 2025.08.04 |
|---|---|
| 유전구형적혈구증 (Hereditary Spherocytosis, HS) - 유전구상적혈구증 원인 유전 증상 진단 (1) | 2025.08.01 |
| 소아청소년 철결핍성 빈혈 (IDA, iron deficiency anemia) 원인 나이 철섭취부족, 모유수유 우유, 출혈 조산 미숙아 (0) | 2025.07.25 |
| 신생아 생리적 빈혈 수치 원인 치료방법 정상 빈혈 수치 (0) | 2025.07.24 |
댓글